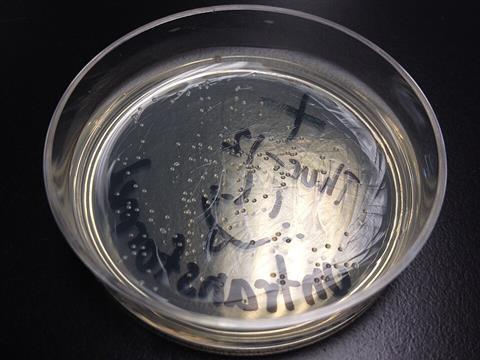
Colonies_of_Escherichia_coli_on_agar_plate

Escherichia coli (E. coli), a type of bacteria commonly found in the human gut, could spread as quickly as swine flu, new research suggests.
For the first time, researchers at the Wellcome Sanger Institute, the University of Oslo, the University of Helsinki, Aalto University in Finland, and their collaborators are able to predict the rate at which one person could transmit gut bacteria to those around them, a calculation that has previously been possible mainly for viruses.
READ MORE: Precision medicine could be possible in the fight against antibiotic resistance
READ MORE: Possible colon cancer vaccine target uncovered in bacteria
The study, published today (4 November) in Nature Communications, investigated three major E. coli strains found in the UK and Norway, two of which are resistant to several commonly used classes of antibiotics. Two of these strains are the most common causes of urinary tract infection and other bloodstream infections in the UK, and also among the most common ones in Norway.
Scientists suggest that tracking these bacteria more effectively could help inform public health measures and prevent treatment-resistant infection outbreaks.
Genetic tools
In the future, understanding more about the genetic tools that some E. coli strains use to spread effectively throughout the population could help develop targeted treatments, and reduce the use of broad-spectrum antibiotics. Additionally, the technique used in this study could be adapted to other bacterial pathogens to further understand and control different invasive infections.
The bacterium, E. coli, is a leading cause of infections worldwide. Most strains of E. coli are harmless and commonly found in the gut. Colonising bacteria, such as E. coli, get into our bodies through direct contact such as kissing, or indirect contact through sharing households, objects or food. However, if the bacterium gets for example into the urinary tract, and further into the bloodstream, it can cause a life threatening sepsis, in particular in people with a weakened immune system.
As an added challenge for healthcare providers, antibiotic resistance has become a frequent feature of such infections. Rates of antibiotic resistance in E. coli vary globally and in the UK, over 40 per cent of E. coli bloodstream infections are resistant to a key antibiotic.
Basic reproduction number
The basic reproduction number, or R0, is a metric that describes how many new infection cases are on average directly caused by one person in a population. It is often used to describe viruses and can be applied to predict whether an infection will continue to spread or die out. Until now, it has not been possible to give colonising gut bacteria, such as E. coli, an R0, as they do not always cause an infection but mostly reside within a person without leading to symptoms.
In this new study, the team analysed E. coli colonisation rates in data from the UK Baby Biome Study and combined these with genomic E. coli bloodstream infection surveillance data from the UK and Norway previously published by the Wellcome Sanger Institute.
The researchers used an inference software platform called ELFI3 (Engine for Likelihood-Free Inference) to build a new model that can predict R0 for the three major strains of E. coli in the UK and Norway.
Rapid spread
They found that one type, ST131-A, can spread as rapidly as viruses that have caused major outbreaks worldwide, such as the swine flu (H1N1), despite E. coli not being transmitted via air droplets.
They also found that the other two strains of E. coli, ST131-C1 and ST131-C2, which are resistant to several classes of antibiotics, are not transmitted rapidly between healthy individuals. However, they do likely have a much higher transmissibility when present in hospitals and other healthcare facilities, meaning these strains could transmit rapidly in such environments, but not outside of this.
Having an R0 allows experts to build understanding about factors influencing transmission, to identify strains that have the biggest risk of disease and inform public health measures to protect those with a weakened immune system.
Simulation model
Fanni Ojala, M.Sc., co-first author at Aalto University in Finland, said: “By having a large amount of systematically collected data, it was possible to build a simulation model to predict R0 for E. coli. To our knowledge, this was not just a first for E. coli, but a first for any bacteria that live in our gut microbiome. Now that we have this model, it could be possible to apply it to other bacterial strains in the future, allowing us to understand, track, and hopefully prevent the spread of antibiotic-resistant infections.”
Dr Trevor Lawley, Group Leader at the Wellcome Sanger Institute, who was not involved in this study but co-led the UK Baby Biome Study at the Wellcome Sanger Institute, said: “E. coli is one of the first bacteria that can be found in a baby’s gut, and in order to understand how our bacteria shape our health, we need to know where we start – which is why the UK Baby Biome study is so important. It is great to see that our UK Baby Biome study data are being used by others to uncover new insights and methods that will hopefully benefit us all.”
Genetic drivers
Professor Jukka Corander, senior author at the Wellcome Sanger Institute and the University of Oslo, said: “Having the R0 for E. coli allows us to see the spread of bacteria through the population in much clearer detail, and compare this to other infections.
”Now that we can see how rapidly some of these bacterial strains spread, it is necessary to understand their genetic drivers. Understanding the genetics of specific strains could lead to new ways to diagnose and treat these in healthcare settings, which is especially important for bacteria that are already resistant to multiple types of antibiotics.”
Topics
- Aalto University
- Bacteria
- colonisation rates
- ELFI3
- Emerging Threats & Epidemiology
- Escherichia coli
- Fanni Ojala
- Gut Microbiome
- Infection Prevention & Control
- Infectious Disease
- Innovation News
- Jukka Corander
- Microbiological Methods
- One Health
- ST131-A
- Trevor Lawley
- UK & Rest of Europe
- University of Helsinki
- University of Oslo
- Wellcome Sanger Institute
No comments yet